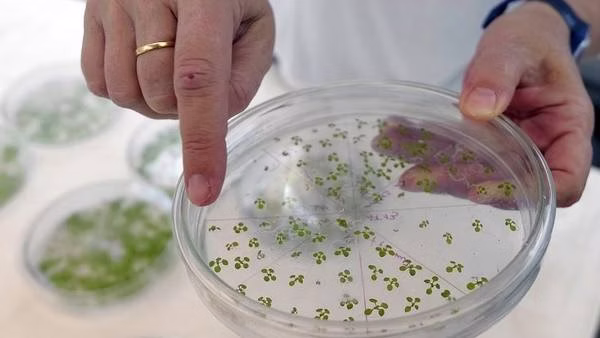
Laboratorio 3

Más de 30 años construyendo un espacio reconocido para el desarrollo de proyectos de investigación científica y tecnológica en Argentina.
El 18 de junio de 1984, en la ciudad de Buenos Aires, se crea, en memoria de Don Pablo Cassará, la entidad de bien público Fundación Pablo Cassará con el objeto de realizar una obra de interés general destinada al desarrollo de la medicina y las ciencias biológicas, colaborando para ello con la investigación, la enseñanza y capacitación.
Los directivos tuvieron como primer propósito contribuir al desarrollo de la medicina para ayudar a las clases menos favorecidas y como segundo propósito el de impartir la enseñanza de la medicina y ciencias biológicas a todos los que conformaron las nuevas generaciones médicas y científicas colaborando para ello con la investigación y capacitación médicas.
Consecuentemente se otorgaron becas y subsidios para la investigación en el área de las ciencias médicas y publicación de manuales y libros tanto para médicos como para estudiantes de medicina. En el área de la docencia, la Fundación Cassará llevó a cabo congresos, simposios, conferencias y jornadas científicas.
A lo largo de sus más de 30 años de vida la Fundación Pablo Cassará logró construir un espacio reconocido para el desarrollo de proyectos de investigación científica y tecnológica en el país.
La Fundación será reconocida por la calidad, la excelencia académica e investigativa en el campo de las ciencias médicas y biológicas, con alianzas estratégicas nacionales e internacionales y apoyada en una infraestructura y cultura innovativa que le permita cumplir con sus objetivos institucionales comprometida con las necesidades de la población.

La Fundación es una institución que asume con responsabilidad el desarrollo de la ciencia, la investigación y la tecnología; con fundamentos de excelencia científica, sentido ético, moral, humanístico y de proyección social; con el fin de permitir el análisis objetivo y racional de los problemas de la comunidad y contribuyendo a mejorar su calidad de vida.
Concretaremos nuestra misión: